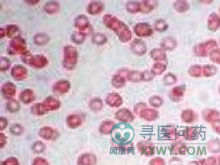
小兒原發性血小板增多症

症狀體徵
起病緩慢,多數為數月至數年。20%患者無症狀,80%可有頭暈、乏力,亦有因術後出血不止或發現脾大才被發現。出血症狀以鼻出血、齒齦出血及消化道出血較多見。皮膚可有瘀斑、少數有泌尿道、呼吸道出血,偶有腦出血死亡者。約1/3患者有靜脈或動脈血栓形成,以肢體多見,可有肢端發涼、怕冷、麻木、酸痛,繼而出現間歇性跛行,最後發展為靜息痛、夜間痛,局部皮色呈紫紅或蒼白、皮溫降低,皮膚乾燥,指趾乾性壞疽。四肢靜脈血栓病變表淺者呈紅腫、青紫、皮溫高,疼痛、壓痛。深靜脈血栓局部疼痛,深血管可摸及索狀物;血栓肢體腫脹、青紫、皮溫低,可有靜脈性壞疽,可發生肝、脾、腸系膜血栓引起腹痛,噁心、嘔吐。80%患者脾大,20%患者可有無症狀的脾梗死而脾萎縮。約40%患者有肝大,肺腦腎等臟器亦可栓塞。
用藥治療
1.血小板清除術 也稱血小板單采術。適用於起病急,病情重,伴有栓塞或出血併發症的患者,目的是迅速降低血小板數,緩解症狀,繼用32P或化療。
2.放射性32P 口服或靜脈注射32P雙基鈉鹽,首劑3~4mCi(毫居里),定期觀察血象,如3個月病情未好轉可再用1劑。一般1個月內血小板開始下降,6~8周達最低值。
3.化療 以烷化劑為主。
(1)羥基脲:目前為首選,它無引起治療相關白血病的報導。適用安全,但起效慢,約4周左右,且應給維持量,否則會反跳。
(2)白消安(馬里蘭):以前作為首選藥物,由於羥基脲廣泛套用,現仍為有效的化療藥。劑量4~6mg/d,待血小板恢復正常時停用或小劑量維持。
(3)氧芬胂(馬法蘭):0.05mg/(kg·d),口服,易引起骨髓抑制,應定期查血象。
(4)苯丁酸氮芥(瘤可寧):0.1~0.15mg/(kg·d),待血小板減少至50%後藥量減半。
(5)氮芥:適用於合併血栓形成之重症者,用量0.4mg/kg,溶於生理鹽水20ml內推入,酌情給小量鎮靜藥。
4.血小板功能抑制藥 小劑量阿司匹林10mg/(kg·d)口服,可減少血栓形成。雙嘧達莫(潘生丁)5mg/(kg·d)口服。
5.干擾素 有抗病毒、抗增殖、有免疫調節、誘導分化、抑制骨髓惡性克隆形成作用。劑量:100~300U/次,隔天皮下注射,待血小板<400×109/L可停用。
飲食保健
飲食宜清淡為主,注意衛生,合理搭配膳食。
預防護理
因病因尚不明確,原發性血小板增多症尚無確切的預防措施。
病理病因
病因不明。血小板計數大於平均值的兩倍標準差(±2SD)以上稱為血小板增多(thrombocytosis)。關於兒童期血小板增多的原因見表1。
通常情況下,體內1/3的血小板滯留於脾臟。外科切除脾臟或功能性脾缺失的患者,雖然全身血小板總數趨於正常,但是血小板計數可增多。因而對於這類脾缺失的患者,出現血小板計數增多屬正常,無需進行治療。與此類似,若注入腎上腺素可以在保持血小板總量不變的情況下,使機體內血小板從脾臟動員入血而產生短暫的血小板升高。血小板計數自發性假性升高還可因球型細胞,Pappenheim小體,紅細胞及白細胞碎片,或者是細菌的存在而引起。
真性血小板增多的原因可分為兩類:原發性血小板增多和反應性(或繼發性)血小板增多。在原發性血小板增多中,血小板的產生對正常調控機制無應答,不會出現在正常情況下由於血小板增多而導致的巨核細胞減少的現象。在兒童期,血小板增多以繼發性因素為主。通常,反應性血小板增多程度輕微,無症狀,經過對原發病因處理可以恢復。反應性血小板增多伴有巨核細胞的增多,增多的程度與原發病因的活動程度呈平行關係,並常與炎症狀態同時出現。例如,鐵缺乏常與血小板計數增加伴發,持續1~2周的輕微血小板增多常繼發於嚴重創傷和外科手術後。這時針對血小板增多而進行的治療並無必要。
血小板增多症的兒童很少出現原發性的骨髓增殖性疾病,如原發性血小板增多或慢性髓系白血病。
疾病診斷
與繼發性血小板增多症、真性紅細胞增多症、骨髓纖維化、惡性腫瘤以及紅白血病鑑別。
檢查方法
實驗室檢查:
1.血液檢查
(1)血小板:血小板顯著增高,多數大於1000×109/L,由於數目過高,計數不準確。有人主張以比積管測定血小板層的高度,即所謂血小板比積,常能較好反映血小板的變化。血片內血小板形態顯著變異,巨大畸形血小板多見。
(2)白細胞:白細胞計數常增高,95%病例在10.0×109/L以上,最高可達60.0×109/L,以中性多形核粒細胞增多為主,血片中可見少量中、晚幼粒細胞。10%患者中性粒細胞內鹼性磷酸酶積分和血清維生素B12濃度降低,25%升高,其餘70%正常。
(3)紅細胞:在疾病某一階段可有不同程度的貧血,一般呈小細胞或正常細胞低色素性,與失血有關。因此低色素性貧血,中性粒細胞增多,結合血小板極度升高,對本病診斷很有意義。
2.骨髓象 增生明顯活躍,以巨核細胞增生尤著,原始與幼稚巨核細胞增多,血小板成堆。
3.血小板功能下降 血小板黏附、聚集、釋放功能減低,出血時間延長,血塊回縮不良,凝血酶原時間和凝血活酶生成時間延長。血小板因子-Ⅲ活力減弱,有效性減低。
其他輔助檢查:
1.毛細血管脆性試驗 根據需要選擇毛細血管脆性試驗,結果陽性。
2.常規做胸片、B超、血管造影、CT等檢查。
併發症
1.內臟出血 多見消化道出血,泌尿道、呼吸道也可發生出血,偶有腦出血死亡者。
2.血栓形成 靜脈或動脈血栓形成,可致乾性壞疽、靜脈性壞疽。脾梗死而脾萎縮,肺腦腎等臟器亦可栓塞。
3.脾大、肝大。
預後
若出現併發症者預後不良。根據血小板增多的程度,病程不一。大多數病例進展緩慢,中位生存期常在10~15年以上。少數病人可轉為骨髓纖維化,真性紅細胞增多症或慢性粒細胞白血病。重要臟器有血栓形成及出血常為本病致死的主要原因。
發病機制
1.克隆性疾病 目前認為本病是一種多能造血幹細胞的克隆性疾病,根據如下:
(1)與骨髓增生綜合徵可互相轉化:本病與慢性粒細胞白血病、真性紅細胞增多症、骨髓纖維化和紅白血病之間關係密切,可合稱為骨髓增生綜合徵,彼此間可以相互轉化,故認為是同一種疾病的不同階段,其機制可能是骨髓內向紅系、粒系、巨核系和成纖維細胞系分化之多能幹細胞水平上的惡性變,導致單個或多個細胞系的惡性增殖。只是不同骨髓增生綜合徵時,主要增生的細胞系列不同而已。一些患者最終可以發展成急性粒細胞白血病。
(2)具有同種同工酶:用G6PD同工酶作為克隆的標誌進行研究,本病患者的紅細胞,中性粒細胞及血小板中具有同一種同工酶,故認為本病是一種多能幹細胞的克羅恩病。
(3)血小板持續增高:本病不僅有持續性骨髓的巨核細胞系增殖,還有髓外浸潤特點,在肝、脾等組織內出現以巨核細胞係為主的增殖灶。骨髓的血小板產生率可增高6倍,加上髓外組織增生,儲存池所釋放的血小板進入血液循環,血小板壽命正常,導致外周血小板持續性極度增高,血小板功能常有異常。
2.血栓形成的機制 由於血小板明顯增多,且功能異常,加上有血管病變存在,極度增多的血小板容易形成血栓,已經活化的血小板可產生TXA2引起血小板聚集和釋放,形成微血管血栓。
3.出血的機制 血栓栓塞區破裂出血,血小板功能異常,此外,血栓形成消耗了過多的凝血因子,造成凝血障礙,造成臨床上出血。